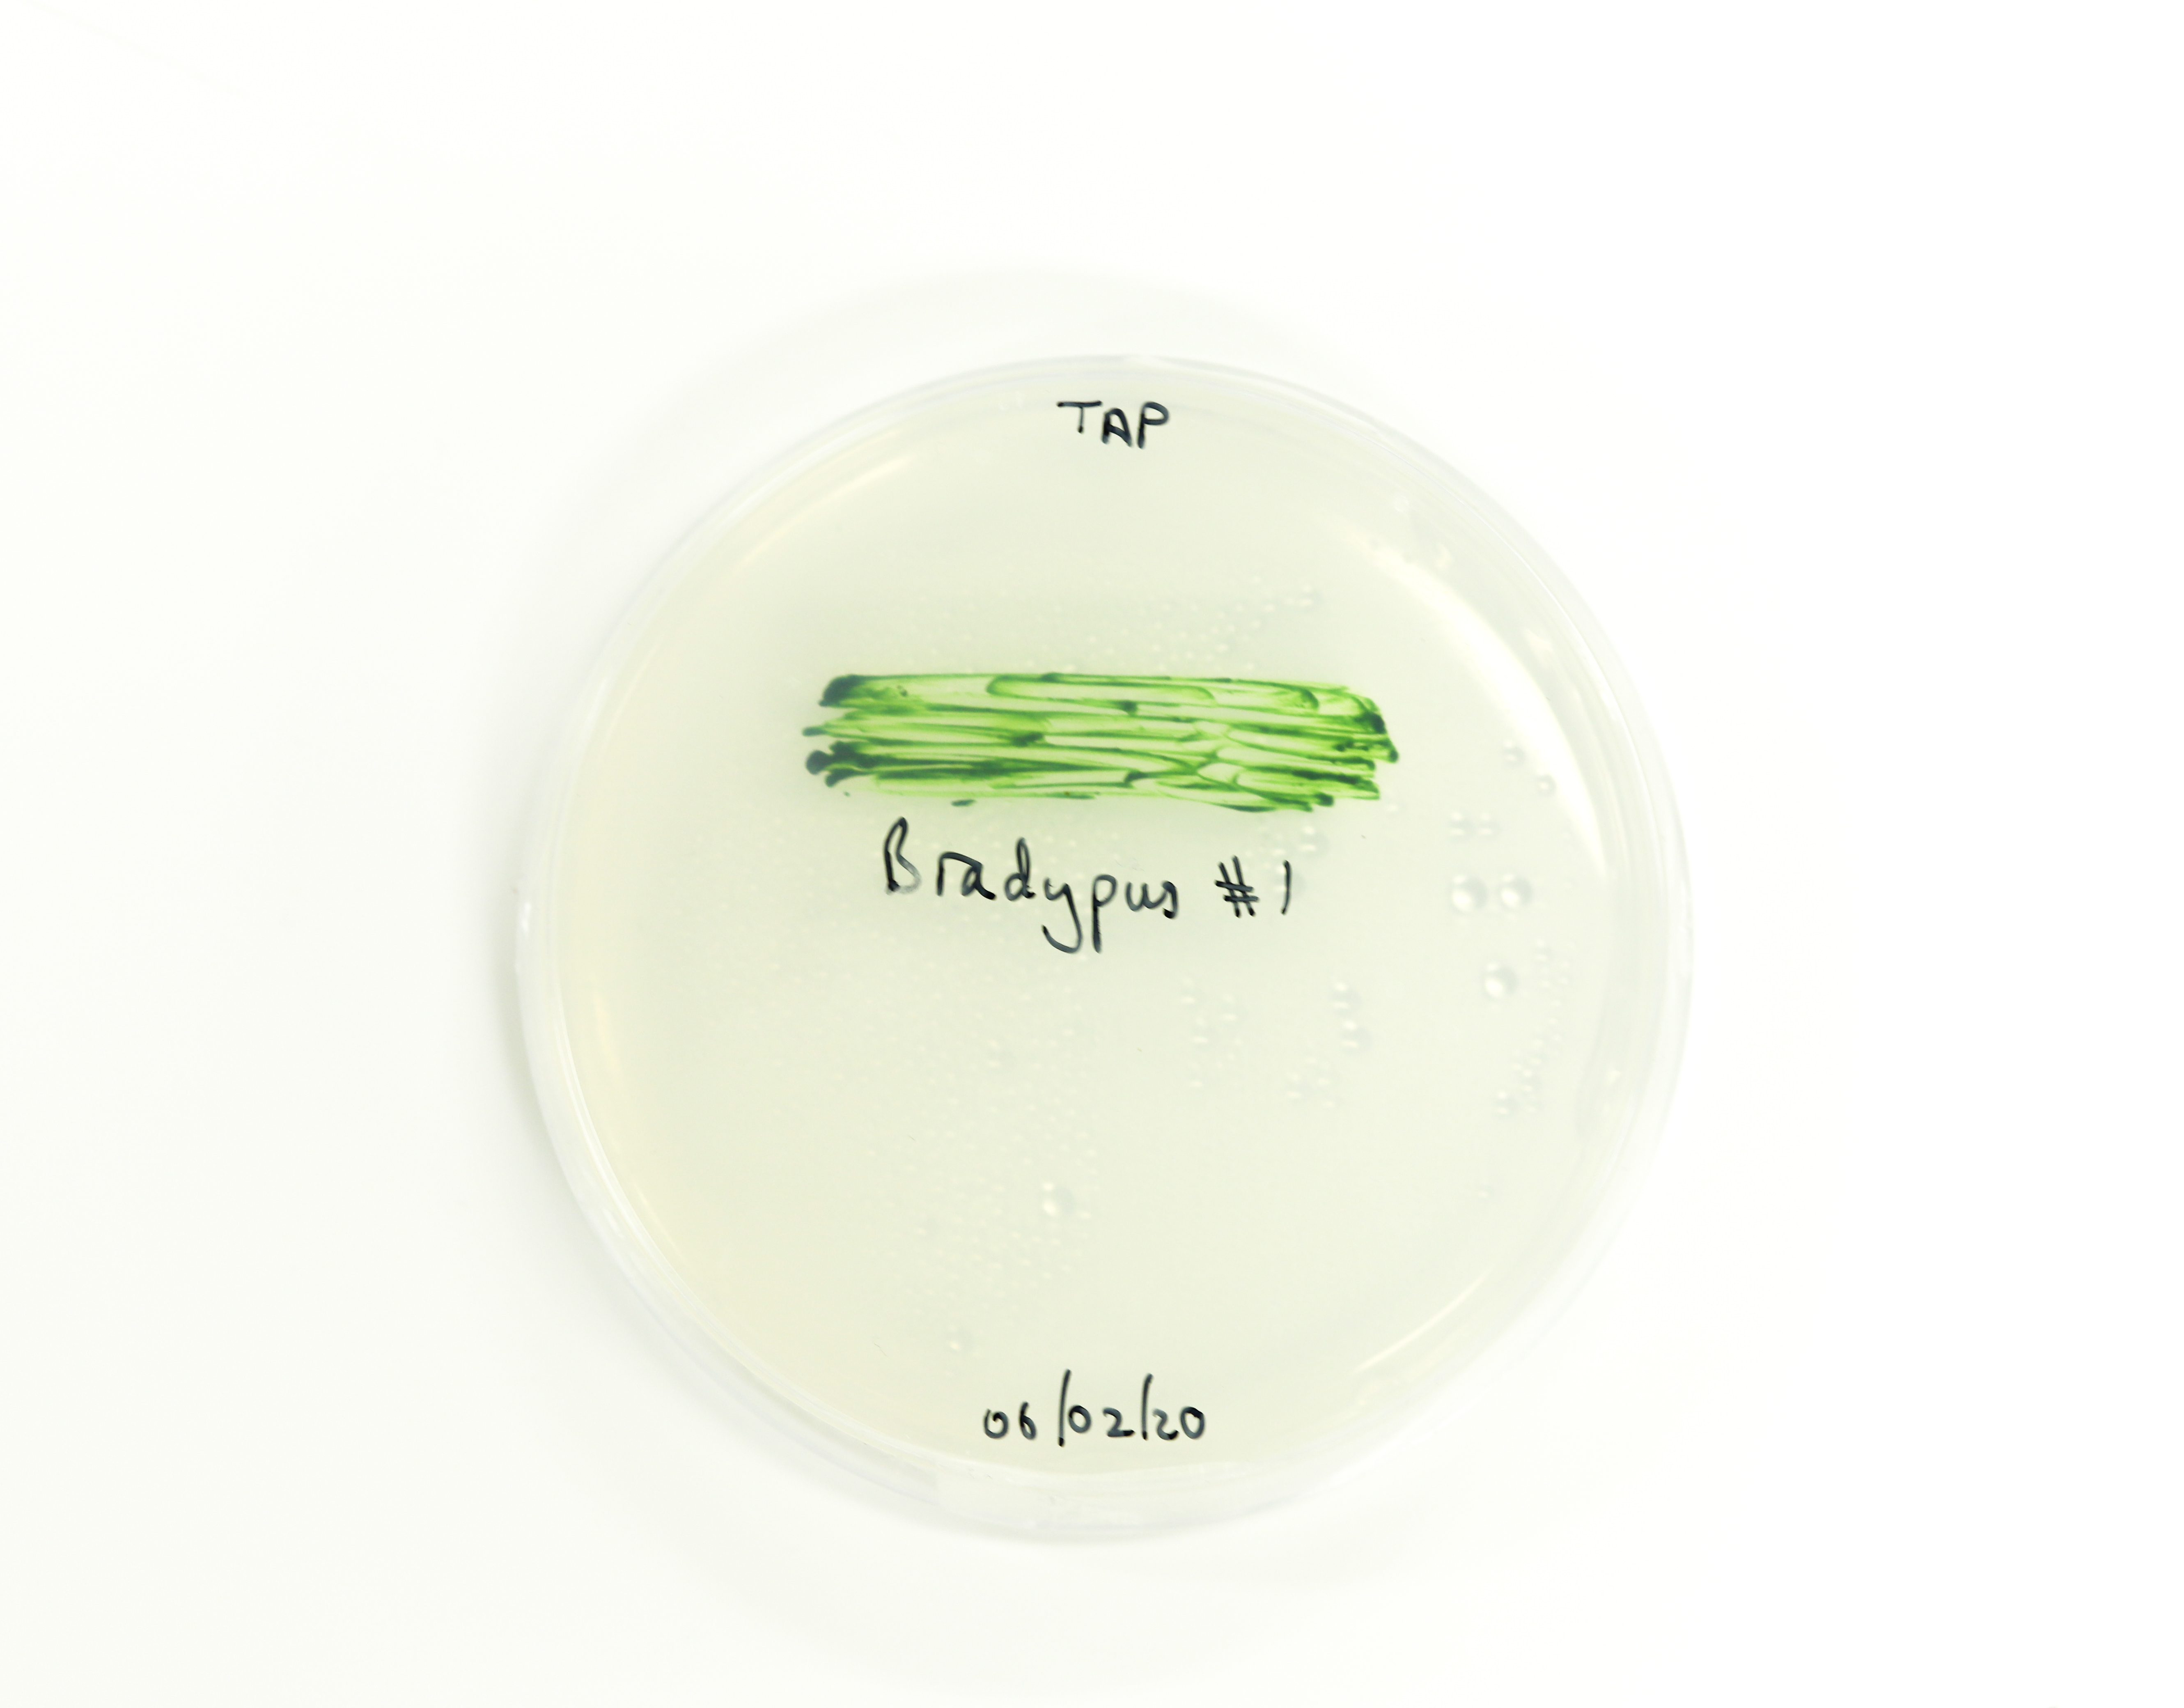

EDF
Services for the energetic transition | UI/UX design

Renault
Products made from car waste | Global design

Terre Volée
Winery in 2074 | Prospectif design

Abeille Noire
Perfumery in 2074 | Prospectif design

Symbeeosis®
Designed with nature in mind | Biodesign

Aura
Luxury fashion industry in 2074 | Prospectif design
Algae Bioreactor
A photobioreactor to bioremediate soil pollution | Biodesign

Bio-materials
A collection of bio-materials | Biodesign

Waste & Growth
Mycelium panels | Biodesign

Bacterial Dyes
New dye technics to counter oceans pollution | Biodesign